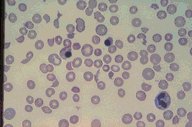

Description
This low power magnification photomicrograph is from the peripheral
blood of a patient with thrombotic thrombocytopenic purpura. The patient
has undergone splenectomy. Nucleated red cells are seen in the center
of the field, as are multiple red cell fragments and significant
anisocytosis and poikilocytosis.
|
|
Click on this image
to enlarge it, then
on Back buttom
in the Netscape Menu
to shrink it back down



|